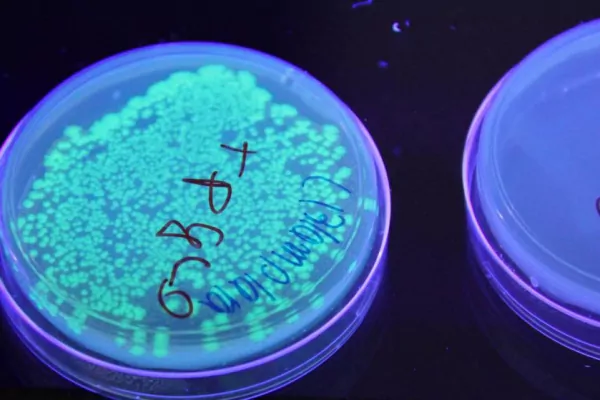
Technologische Fachoberschule Bruneck

Technologische Fachoberschule Bruneck
Unsere Schule ist eine fünfjährige, technisch ausgerichtete Oberschule, die sowohl einen unmittelbaren Berufseinstieg als auch ein Weiterstudium ermöglicht. Nach Abschluss des Bienniums, in dem sich sprachliche, allgemeinbildende und naturwissenschaftlich-technische Fächer das Gleichgewicht halten, wird die Möglichkeit geboten, sich ein solides Fachwissen in einer ausgewählten Fachrichtung anzueignen. Eine sehr gute Ausstattung der Schule und die Bereitschaft zu Innovation sind die Grundlagen unserer Arbeit. Eine enge Verbindung von Theorie und Praxis ist uns wichtig. Außerdem legen wir Wert auf selbstständiges Arbeiten und eigenverantwortliches Handeln. Dennoch unterstützen wir uns gegenseitig bei der Ausübung unserer Tätigkeiten. Wir sind ein aufgeschlossenes Team, das seine Professionalität durch fachliche und pädagogisch-didaktische Fortbildung weiterentwickelt. Wir pflegen Kontakt zu Eltern, Arbeitswelt, anderen Schulen und außerschulischen Institutionen. Nach diesem Leitbild bemühen wir uns um Transparenz. So können wir sicherstellen, dass an unserer Schule ein von gegenseitiger Wertschätzung geprägtes Klima herrscht.

Fachrichtungen:
- Chemie, Werkstoffe und Biotechnologie
- Elektronik und Elektrotechnik
- Maschinenbau, Mechatronik und Energie
Sito web Trova il tuo abbinamento! Informazioni su Technologische Fachoberschule Bruneck dell` Ufficio Orientamento scolastico & professionale.